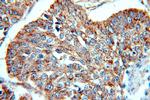
Cytokeratin 10 Antibody in Immunohistochemistry (Paraffin) (IHC (P))

Search
Proteintech
Cytokeratin 10 Polyclonal Antibody
{{$productOrderCtrl.translations['antibody.pdp.commerceCard.promotion.promotions']}}
{{$productOrderCtrl.translations['antibody.pdp.commerceCard.promotion.viewpromo']}}
{{$productOrderCtrl.translations['antibody.pdp.commerceCard.promotion.promocode']}}: {{promo.promoCode}} {{promo.promoTitle}} {{promo.promoDescription}}. {{$productOrderCtrl.translations['antibody.pdp.commerceCard.promotion.learnmore']}}
图: 1 / 13
Cytokeratin 10 Antibody (16855-1-AP) in IHC (P)

产品信息
16855-1-AP
种属反应
宿主/亚型
分类
类型
抗原
偶联物
形式
浓度
纯化类型
保存液
内含物
保存条件
运输条件
产品详细信息
This antibody is specifically against KRT10.
靶标信息
Cytokeratins (CK) are intermediate filaments of epithelial cells, both in keratinizing tissue (i.e., skin) and non-keratinizing cells (i.e. mesothelial cells). Although not a traditional marker for endothelial cells, cytokeratins have also been found in some microvascular endothelial cells. At least 20 different cytokeratins (CK) in the molecular range of 40-70 kDa and isoelectric points of 5-8. 5 can be identified using two dimensional gel electrophoresis. Biochemically, most members of the CK family fall into one of two classes, type I (acidic polypeptides) and type II (basic polypeptides). At least one member of the acidic family and one member of the basic family is expressed in all epithelial cells. Monoclonal antibodies to cytokeratin proteins can be useful markers for tumor identification and classification.
仅用于科研。不用于诊断过程。未经明确授权不得转售。
篇参考文献 (0)
生物信息学
蛋白别名: CK-10; CK-17; cytokeratin 10; Cytokeratin-10; cytokeratin-17; K10; keratin 10, type I; Keratin, type I cytoskeletal 10; Keratin-10; keratin-17
基因别名: BCIE; BIE; CK10; EHK; K10; KPP; KRT10
UniProt ID: (Human) P13645
Entrez Gene ID: (Human) 3858



